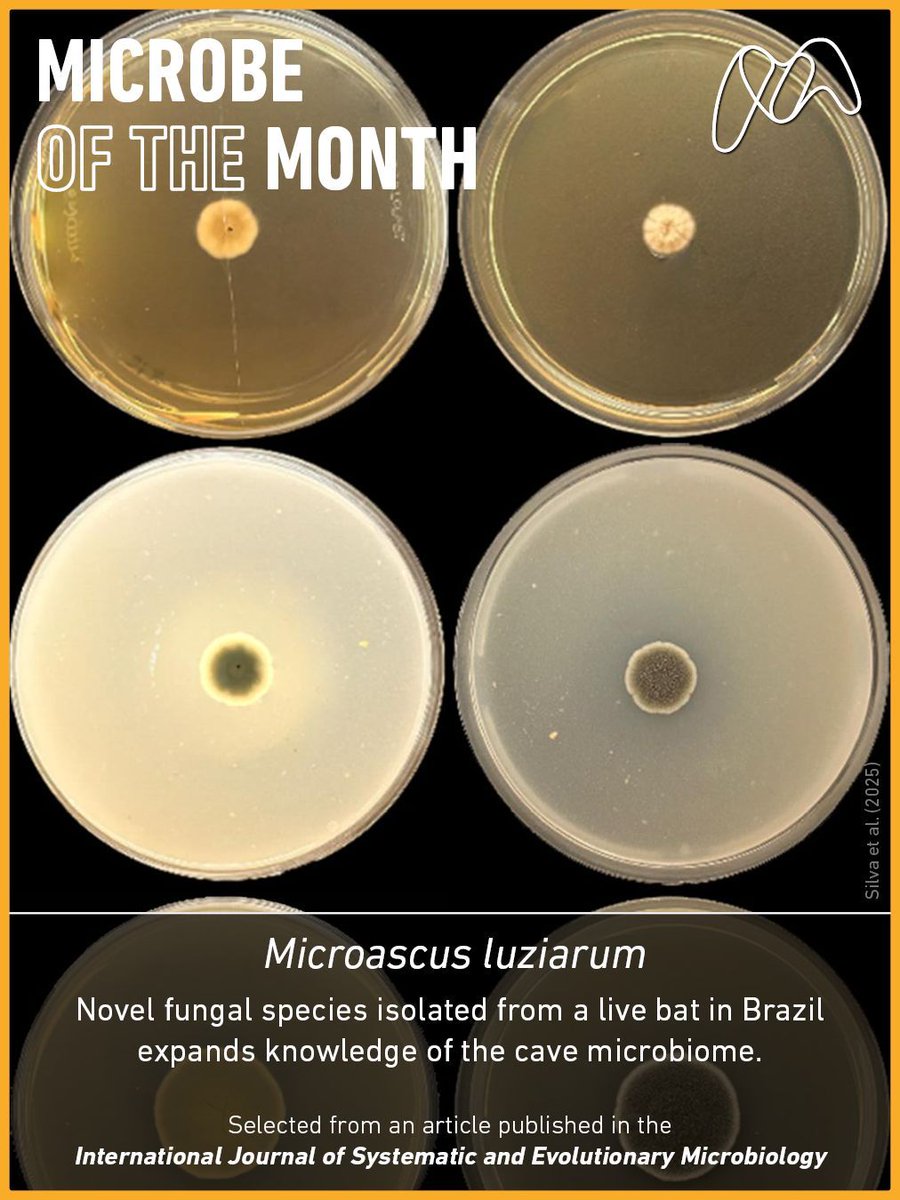
Pinch, punch, it's Microbe of the Month 🦠 Introducing Microascus luziarum!

The novel fungus was found on a bat caught by a hand net while scientists were surveying caves in northeastern Brazil. Talk about a catch!

Find out more in our latest blog microb.io/48mSgQO🧫

Micro Industrial
@umh1399
Twitter oficial de la asignatura de Microbiología Industrial de la UMH. Mejor manda un email si quieres contactar con el profesor (@ManoloSanchezA).
ID: 1208313913
http://umh1399.edu.umh.es/ 22-02-2013 12:47:12
4,4K Tweet
368 Followers
71 Following

Ya han salido los resultados de las encuestas de docencia. En #MicroIndustrial (Micro Industrial) el grado de satisfacción con la labor docente ha sido de 8,25. Muchas gracias a todos aquellos estudiantes que participaron en la encuesta.